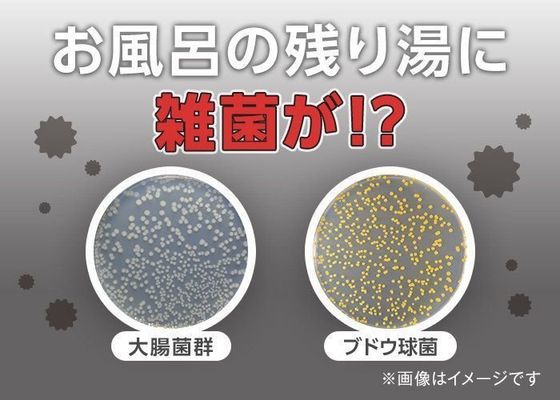

1日の汗や汚れを洗い流してリラックスできるバスタイム。でも、気持ちよくつかっているつもりのお風呂のお湯に雑菌がいるとしたら? 今回はお風呂のお湯に潜む雑菌と健康への影響、そして清潔に保つポイントについて、東京医科歯科大学 小児科医の松浦恵先生にお聞きしました。

ひと晩で約1000倍に!?残り湯の雑菌はフロ釜でさらに増殖!
昔に比べると断然使いやすく進化した最近のお風呂。中でも追いだき機能がついたフロ釜の登場は、お湯はりやあたためをより手軽なものにしてくれました。でも、便利な追いだき機能つきのフロ釜が、お風呂のお湯に潜む雑菌をより増殖させる原因にもなっているのだとか。
「入浴後のお湯には、大腸菌群やブドウ球菌などさまざまな菌が存在します。
ヒトの皮膚にはもともと一定数の菌(常在菌)がいて、入浴することでそれらの菌がお風呂のお湯に移ります。菌は同じようにお湯に溶け込んだ汗や皮脂などを栄養源として増殖するため、放置された残り湯は雑菌が増殖しやすい環境といえます。
さまざまな調査によれば、菌の種類にもよりますが、残り湯の雑菌は翌日には約1000倍にもなると言われています。残り湯を追いだきするとそれらの雑菌はフロ釜に流れ込み、フロ釜の汚れをエサにさらに増殖。お湯と一緒に再び浴槽に戻ってくる悪循環が生まれてしまうのです」(松浦先生)
免疫力が弱い乳幼児や高齢者には注意が必要
フロ釜で増殖した雑菌が流れ込んでいる可能性があるお風呂に入っているなんて、ゾッとしますね。健康面への影響はあるのでしょうか?
「お風呂のお湯に潜む雑菌のいくつかは、もともとヒトの皮膚に由来する菌(常在菌)なので、健康な大人がつかる分には心配はありません。ただ、乳幼児や高齢者、免疫力が低下している方には健康への影響があることも。とくに、浴槽のお湯で顔や頭を洗ったり、子どもがお湯に潜って遊んだりする際に口に入る可能性がある場合は、注意したいですね」(松浦先生)
定期的なフロ釜除菌で、清潔なバスタイムを

健康な大人ならば、健康への影響はそれほど心配する必要はないというものの、やはり衛生面は気になります。清潔なお風呂を保つためにはどのようにすればいいのでしょうか?
「お風呂のお湯の衛生管理は、フロ釜に潜む雑菌がお湯はりや追いだきをするたびに浴槽へ流れ出るという悪循環を断ち切ることが肝心です。そのためには、フロ釜を定期的に除菌することが最善策と言えるでしょう。
お風呂のお湯を毎日はりかえている、追いだきはしない、という場合でも、フロ釜の中には前日のお湯が残っている可能性があります。新しくお湯をはるときもフロ釜を通して水を温めるため、追いだき配管を清潔に保つことは重要です。
家族のためにも、月に1度程度の定期的なフロ釜除菌でお風呂の清潔を保ってあげてくださいね」(松浦先生)
医師たちも推奨!97%がフロ釜洗浄を習慣化したいと回答

今回お話を伺った松浦恵先生も監修として参加している、ヘルスケアサービス「Doctors Me」(ドクターズミー)。医師、薬剤師をはじめとする500名以上の専門家に直接相談できるオンライン健康相談を軸に、病気・薬情報や健康に役立つコラムなど豊富な情報を提供しています。ドクターズミー登録医師100名にアンケートをとったところ、実に97%の医師が月1回のフロ釜洗浄を勧めたいと答えました。
▼家族のために月イチの「ジャバ活」で清潔なお風呂を保とう!